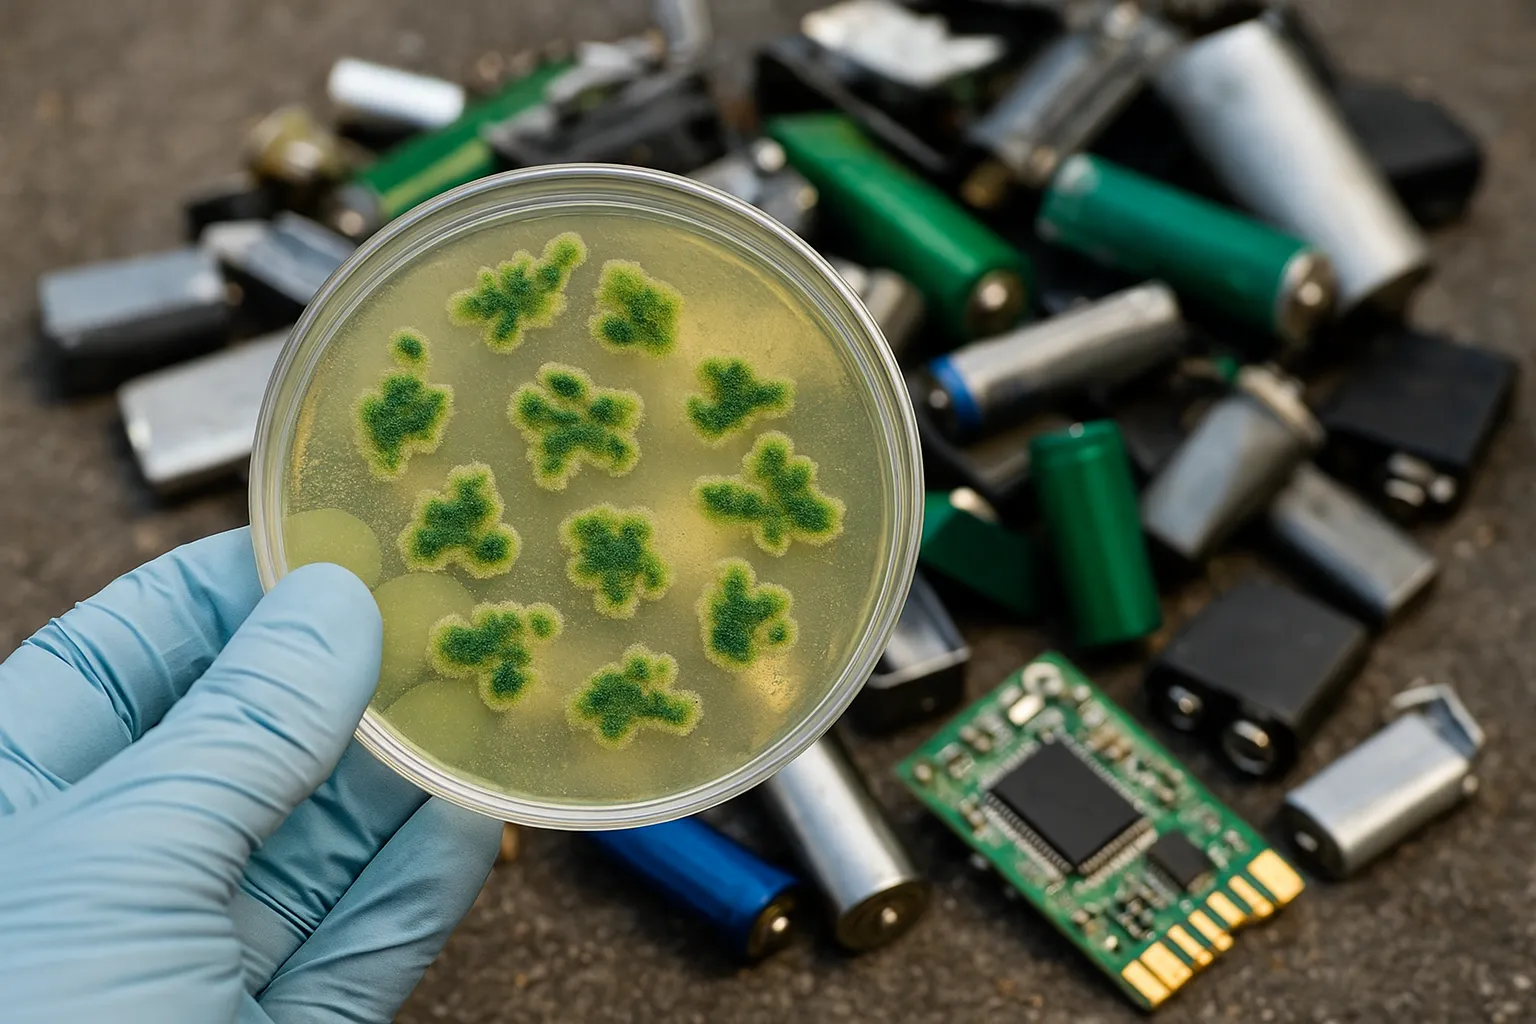

بكتيريا تتغذى على البطاريات.. اكتشاف ثوري لإعادة التدوير المستدام
علماء يبتكرون طريقة بيولوجية صديقة للبيئة لتحويل النفايات الإلكترونية إلى مواد قابلة لإعادة الاستخدام
كشف باحثون من كلية بوسطن الأمريكية عن اكتشاف علمي غير مسبوق يتمثل في بكتيريا قادرة على التغذي على مكونات البطاريات المستهلكة والنفايات الإلكترونية، ما يمهد الطريق أمام ثورة جديدة في تقنيات إعادة التدوير البيئي المستدام.
وأوضح الفريق البحثي أن البكتيريا المكتشفة، وتُعرف علميًا باسم Acidithiobacillus ferrooxidans، تستفيد من الحديد الموجود في البطاريات داخل بيئة حمضية خاصة، حيث تعمل على إذابة المكونات وتحويلها إلى محلول مغذٍ يمكن استخراج الكاثودات منه لإنتاج بطاريات جديدة دون استخدام المواد الكيميائية السامة التي تُستخدم عادة في عمليات التدوير الصناعية.
وبيّنت الدراسة أن هذه التقنية تمثل بديلًا آمنًا واقتصاديًا وصديقًا للبيئة، خصوصًا مع الارتفاع العالمي في الطلب على البطاريات وتزايد تحديات التخلص من النفايات الإلكترونية. كما أثبتت النتائج أن الكاثودات المنتجة بهذه الطريقة تتمتع بكفاءة مماثلة للبطاريات التقليدية، ما يعزز جدوى هذا الابتكار في خفض الانبعاثات وتحقيق الاستدامة البيئية.
الكلمات الدلالية



